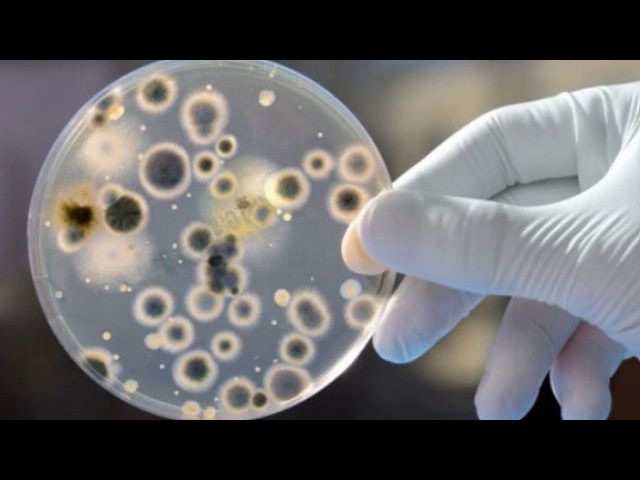
Плесень - эволюция и классификация. Рассказывает биолог Визма Николаева

Существует огромное множество разнообразных видов плесни, которые отличаются не только внешним видом, но и строением, способом размножения, средой обитания, степенью опасности для человека.
Описание плесени: что это такое?
О том, что плесень – это вредоносный микроорганизм, знают все, но многие путаются, к какой категории его отнести – к грибам или бактериям. Несмотря на то, что структура плесени очень проста, она все же сложнее бактерий. Совершенно однозначно плесень – это грибок.
Плесень или плесневые грибы – такое название имеет многочисленная группа микроорганизмов, особенность которых в том, что они образуют ветвящиеся грибницы без больших плодовых тел. В зависимости от того, к какой разновидности принадлежит грибок, отличается и состав плесени. От него в частности зависит, в какой среде лучше всего размножается микроорганизм, как он выглядит, как воздействует на человека.
В роду плесневых грибов множество разновидностей, которые проще всего отличить по цвету. Если же классифицировать плесень по-научному, то все виды можно разделить на одноклеточные (зигомицеты) и многоклеточные (аскомицеты).
Строение всех видов плесени очень похоже. Плесневый гриб состоит из мицелия (грибницы), который выглядит как скопление тончайших нитей, называемых гифами, а также спорангиев (в них находятся необходимые для размножения споры).
Врачи отмечают, что плесень представляет собой разнообразную группу грибов, которые могут развиваться в различных условиях. Существует множество видов плесени, среди которых наиболее известны Aspergillus, Penicillium и Cladosporium. Эти микроорганизмы могут быть как полезными, так и вредными для здоровья человека. Например, некоторые виды используются в производстве антибиотиков и сыров, в то время как другие могут вызывать аллергические реакции и респираторные заболевания.
Состав плесени включает в себя споры, мицелий и метаболиты, которые могут быть токсичными. Врачи подчеркивают, что длительное воздействие плесени может привести к серьезным проблемам со здоровьем, особенно у людей с ослабленным иммунитетом. Свойства плесени варьируются в зависимости от вида, но общими чертами являются способность к быстрому размножению и устойчивость к неблагоприятным условиям. Поэтому важно контролировать уровень влажности в помещениях и своевременно устранять источники плесени, чтобы минимизировать риски для здоровья.

Условия появления
Споры плесневых грибов очень мелкие, невидимые невооруженным взглядом. Они находятся везде вокруг нас – в воздухе, почве, на растениях и предметах, легко переносятся с воздушными массами.
Где живет плесень, зависит от вида грибка. Одна предпочитают растения, другая – древесину, третья – злаковые культуры. А вот причины появления плесневого налета для всех грибков одинаковы. Стоит спорам попасть в благоприятные условия, как они начинают активно размножаться.
Плесень образуется благодаря таким фактора как:
- наличие питательной среды;
- повышенная влажность;
- отсутствие циркуляции воздуха;
- комфортная температура.
Что касается последнего пункта, то для большинства грибков комфортна температура +18…22⁰С. Однако некоторые разновидности во влажной питательной среде могут размножаться даже при температуре чуть выше 0⁰С.
Виды плесени
Различать плесневые грибки по строению и составу – удел ученых. Обычные люди чаще всего ориентируются на цвет плесени. И действительно окраска налета может многое сказать об основных свойствах и опасности того или иного грибка.
Плесень — это грибковая форма жизни, которая вызывает множество обсуждений среди людей. Многие отмечают, что плесень может быть как полезной, так и вредной. Например, некоторые виды, такие как Penicillium, используются в медицине для производства антибиотиков, тогда как другие, например, Aspergillus, могут вызывать аллергические реакции и заболевания. Состав плесени разнообразен: она состоит из мицелия, спор и клеточных стенок, содержащих хитин. Люди также подчеркивают, что плесень предпочитает влажные и теплые условия, что делает ее распространенной в домах с плохой вентиляцией. Свойства плесени включают способность к быстрому размножению и образованию спор, что позволяет ей выживать в неблагоприятных условиях. Важно помнить, что контроль за плесенью в помещениях — это не только вопрос эстетики, но и здоровья.

Чёрная плесень
Черная плесень – один из видов, которые чаще всего обнаруживаются в квартирах и частных домах. Ее появление обусловлено высоким уровнем влажности, плохой вентиляцией, перепадами температур. Черные или темно-серые пятна чаще всего появляются в ванных, на потолках или стенах в подвалах, на балконах.
Черная плесень – одна из наиболее агрессивных, быстро размножающихся и опасных для человека разновидностей. Она вызывает заболевания дыхательных путей, кожные и суставные болезни, аллергию.
Белая плесень
Белая плесень – это еще один распространенный вид. Чаще всего она поражает растения, некоторые продукты (хлебобулочные изделия, сыр, фрукты и ягоды), встречается на почве, в помещениях. Белая плесень выглядит как светлый пух, покрывающий пораженный участок. Она не так агрессивна, как черная, но может спровоцировать сильную аллергию.
Некоторые виды белой плесени полезны. Их используют в пищевой промышленности (например, при производстве элитных сыров, сыровяленых колбас, картофельного этанола), в фармацевтической промышленности (для изготовления антибиотиков).
Зелёная
Зелёная плесень – это довольно многочисленная группа грибков, часть из которых считается условно патогенными, тогда как другая часть относится к токсичным. К этому виду плесени относится известнейший пеницилл, который используют при производстве антибиотика пенициллина.
Плесень зеленого цвета относится к категории самых распространенных. Ее можно увидеть на продуктах, на растениях, в почве, в помещениях. Особенно опасна зеленая плесень людям с ослабленным иммунитетом.
Оранжевая
Оранжевая плесень встречается довольно редко. Некоторые ученые считают, что это относительно новый вид, появившийся в процессе мутации уже известных плесневых грибов. Оранжевая плесень иногда обнаруживается на сырых стенах, хлебобулочных изделиях, некоторых продуктах. Сразу после появления, налет пастообразный, но со временем высыхает, превращаясь в порошок, похожий на ржавчину, и начинает издавать неприятный запах. Этот вид грибка относится к высокотоксичным.
Розовая плесень
Плесень розового цвета чаще всего образуется колонией грибов, относящихся к роду Фузариум. Представители этого вида поражают растения (семена и плоды), в частности зерновые культуры, корнеплоды. Кроме того, розовый грибок представляет опасность для животных и человека, вызывая токсикозы, дерматиты. У людей после употребления зерна, зараженного розовой плесенью, может развиться септическая ангина.
Синяя
К синей плесени можно отнести 2 разновидности. Одна из них – голубая, так называемая «благородная» плесень, которую нередко используют в пищевой промышленности, например, для изготовления пикантных сыров. Голубая плесень встречается на растениях, на почве, на разлагающейся органике.
Другой вид – это грибок синевы, который в основном развивается внутри древесины, вызывая не только изменение цвета, но и гниение. Он часто поражает деревянные конструкции в домах, мебель и изделия из дерева.
Серая
Серая плесень тоже относится к опасным, высокотоксичным разновидностям. Чаще всего этот грибок развивается на растениях, особенно тех, которые содержат большое количество глюкозы. Серая плесень быстро размножается, вызывает гниение самого растения и его плодов. Для человека серая плесень опасна из-за высокого риска отравления, негативного влияния на иммунную систему.
Красный грибок
Плесень красного цвета можно обнаружить на некоторых растениях, кило-молочных продуктах, иногда на отсыревших поверхностях в помещениях. Есть плесневые грибки, для которых красный цвет – норма. Но иногда под воздействием определенных веществ краснеют виды белой или желтой плесени. Так, например, некоторые разновидности пеницилла белые изначально краснеют под воздействием кислот.
Желтая плесень
Желтый грибок иногда можно обнаружить на молочных продуктах, рыбе, хлебе, арахисе. Изредка желтая плесень развивается на стенах в сырых помещениях, чаще всего на штукатурке или обоях. Эта разновидность очень опасна, особенно для детей и пожилых людей. Контакт с желтой плесенью может стать причиной аллергии, нарушения работы ЖКТ и печени.
Особенности размножения
Размножение плесневых грибов может происходить тремя способами:
- бесполый (с помощью спор);
- вегетативный (с помощью отделившихся частей грибницы);
- половой.
Большинство разновидностей в зависимости от условий может размножаться любым из них, но определенным видам грибков доступны не все способы.
Если плесень находится в благоприятных условиях с достаточным количеством питательных веществ и высоким уровнем влажности, происходит размножение спорами. Они развиваются в специальных хранилищах спорангиях. Когда споры созревают, оболочка лопается. Споры разносятся по воздуху и, попадая в подходящие условия, начинают активно размножаться.
Возможет вариант, когда споры долгое время находятся в неблагоприятной среде. Они не развиваются, но сохраняют жизнеспособность. Как только условия изменятся, споры сразу же прорастают.
В случае вегетативного размножения плесневого гриба от мицелия отделяются небольшие части, которые могут существовать самостоятельно. С них начинается развитие новой колонии.
Половое размножение происходит, когда гифы одной или разных грибниц соприкасаются, в результате чего половые клетки соединяются, образуя зиготу. После полного созревания клетки, из нее появляется зародышевый мицелий, который и даст начало новой полноценной грибнице.
Заключение
По приблизительной оценке, на сегодняшний день насчитывается около 100 тысяч разновидностей плесневых грибов. Ученые постоянно обнаруживают новые виды, обладающие уникальными свойствами. С большой долей вероятности можно утверждать, что на Земле существует еще немало видов плесени, о которых ученым ничего не известно, так что вполне возможно, что все самые интересные открытия еще впереди.
Вопрос-ответ
Какие бывают виды плесени?
Черная плесень — очень опасный паразит, плотно соседствующий с человеком. Она не только портит имущество, но и отрицательно влияет на здоровье.
БЕЛАЯ ПЛЕСЕНЬ
Белая плесень (penicillium candidum) предпочитает теплые места с повышенной влажностью, такие как полуподвальные, подвальные помещения и погреба.
Что входит в состав плесени?
Класс грибов насчитывает 100 000 видов грибов, включая шляпочные грибы, ложномучнистую росу и дрожжи, ржавчинные грибы. Плесень, или грибок микроскопический, состоит из нитей – это так называемые грифы различной длины и толщины, которые, разветвляясь и переплетаясь, образуют грибницу, или мицелий.
Каковы свойства плесени?
Плесень лучше всего растёт в тёплых, влажных и сырых условиях, распространяясь и размножаясь посредством спор. Споры плесени способны выживать в суровых условиях окружающей среды, например, в сухой, которая не способствует нормальному росту плесени. Плесень появляется в зданиях, если воздух в помещении очень влажный или есть протечки воды.
Сколько видов плесени в мире?
В мире насчитывается более 10 000 видов плесневых грибов. Здесь представлены красивые фотографии различных плесневых грибов. Если Вы не хотите, чтобы похожие “красавцы” жили рядом с Вами, то читайте, как избавиться от плесени.
Советы
СОВЕТ №1
Изучите основные виды плесени, чтобы понимать, какие из них могут быть опасны для здоровья. Например, некоторые виды плесени могут вызывать аллергические реакции или респираторные заболевания, поэтому важно знать, как их распознать.
СОВЕТ №2
Регулярно проверяйте влажные места в вашем доме, такие как ванные комнаты и кухни, на наличие плесени. Поддержание низкого уровня влажности (ниже 60%) поможет предотвратить ее появление.
СОВЕТ №3
При обнаружении плесени не откладывайте ее удаление. Используйте специальные средства для удаления плесени или растворы на основе уксуса и воды, чтобы эффективно очистить пораженные участки и предотвратить повторное появление.
СОВЕТ №4
Обратите внимание на состав материалов, используемых в вашем доме. Выбирайте антимикробные и влагостойкие материалы, чтобы снизить риск появления плесени в будущем.









